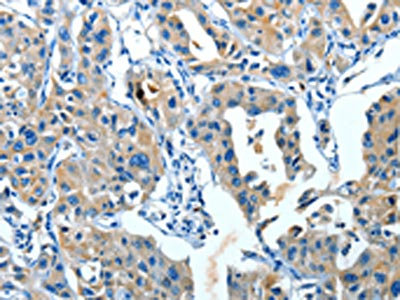

SERPINA3 Antibody
-
中文名稱:SERPINA3兔多克隆抗體
-
貨號:CSB-PA879441
-
規格:¥1100
-
圖片:
-
其他:
產品詳情
-
Uniprot No.:
-
基因名:SERPINA3
-
別名:SERPINA3 antibody; AACT antibody; AACT_HUMAN antibody; ACT antibody; alpha 1 Antichymotrypsin antibody; Alpha-1-antichymotrypsin His-Pro-less antibody; Antichymotrypsin antibody; Cell growth inhibiting gene 24/25 protein antibody; Cell growth-inhibiting gene 24/25 protein antibody; GIG24 antibody; GIG25 antibody; Growth inhibiting protein 24 antibody; Growth inhibiting protein 25 antibody; MGC88254 antibody; Serine (or cysteine) proteinase inhibitor clade A (alpha 1 antiproteinase; antitrypsin) member 3 antibody; Serine (or cysteine) proteinase inhibitor clade A member 3 antibody; Serine proteinase inhibitor clade A member 3 antibody; Serpin A3 antibody; Serpin family A member 3 antibody; Serpin peptidase inhibitor clade A (alpha 1 antiproteinase antitrypsin) member 3 antibody; SERPINA3 antibody
-
宿主:Rabbit
-
反應種屬:Human
-
免疫原:Fusion protein of Human SERPINA3
-
免疫原種屬:Homo sapiens (Human)
-
標記方式:Non-conjugated
-
抗體亞型:IgG
-
純化方式:Antigen affinity purification
-
濃度:It differs from different batches. Please contact us to confirm it.
-
保存緩沖液:-20°C, pH7.4 PBS, 0.05% NaN3, 40% Glycerol
-
產品提供形式:Liquid
-
應用范圍:ELISA,IHC
-
推薦稀釋比:
Application Recommended Dilution ELISA 1:2000-1:5000 IHC 1:25-1:100 -
Protocols:
-
儲存條件:Upon receipt, store at -20°C or -80°C. Avoid repeated freeze.
-
貨期:Basically, we can dispatch the products out in 1-3 working days after receiving your orders. Delivery time maybe differs from different purchasing way or location, please kindly consult your local distributors for specific delivery time.
-
用途:For Research Use Only. Not for use in diagnostic or therapeutic procedures.
相關產品
靶點詳情
-
功能:Although its physiological function is unclear, it can inhibit neutrophil cathepsin G and mast cell chymase, both of which can convert angiotensin-1 to the active angiotensin-2.
-
基因功能參考文獻:
- SERPINA3 silencing inhibits the migration, invasion, and liver metastasis of colon cancer cells. PMID: 29855767
- evaluation of serum proteins reveals that SERPINA1, SERPINA3 and SERPINC1 could be useful to discriminate healthy from colorectal carcinoma patients with a high sensitivity and specificity PMID: 27492143
- This study confirms the prognostic potential of SERPINA3 expression in human cutaneous melanoma PMID: 27213583
- AACT is downregulated in NSCLC. The GlcNAcylated AACT can effectively differentiate Stage I non-small cell lung cancer from healthy or benign lung disease samples. PMID: 26908325
- The ACT gene (also named SERPINA3) was mapped on chromosome 14q32.1 We studied the association between Alpha-1 antichymotrypsin (ACT) signal peptide A/T polymorphism polymorphism and risk of primary intracerebral hemorrhage PMID: 26210716
- Proteome demonstration of alpha-1-acid glycoprotein and alpha-1-antichymotrypsin candidate biomarkers for diagnosis of enterovirus 71 infection PMID: 25170552
- SERPINA3 promotes endometrial cancer cells growth by regulating G2/M cell cycle checkpoint and apoptosis. PMID: 24817931
- ACT-17 variation presents a risk factor for Alzheimer's disease in the worldwide population, especially in the Caucasian population. PMID: 22272609
- This study demonistrated that SERPINA3 is changed in the dorsolateral prefrontal cortex of individuals with schizophrenia PMID: 22869038
- Prostate specific antigen (PSA) forms complexes with alpha1-antichymotrypsin (ACT) within the prostate, which may explain, at least partially, why the ratio of serum PSA-ACT to total PSA is increased in prostate cancer. PMID: 22806587
- the promoter of SERPINA3 is transcriptionally activated by three transcription factors (SP1, MZF1 and ZBTB7B) PMID: 22246292
- The common alpha1-antichymotrypsin signal peptide -15A/T polymorphism may not be a major risk factor for Alzheimer disease (AD) but the polymorphism is capable of increasing late onset AD risk. [Meta-analysis] PMID: 22294107
- Pivotal role for alpha1-antichymotrypsin in skin repair PMID: 21693707
- alpha-1 antichymotrypsin C-terminal fragment and Apo A1 provide a plasma molecular profile, and this is associated with acute cellular renal allograft rejection. PMID: 21730889
- human plasma serine protease inhibitor alpha(1)-antichymotrypsin inhibits staphopain C PMID: 21296644
- The Alpha 1 antichymotrypsin is an independent histological prognostic marker for patients with Melanoma, especially those with Stage III melanoma. PMID: 20444200
- Found a marked and persistent coronary artery bypass grafting (CABG) postoperative increase in the levels of the serpin-protease inhibitor alpha(1)-antichymotrypsin that fully maintains the inhibitory activity blunting its protease substrate cathepsin G. PMID: 20302328
- The study concluded that the effect of the variations in the alpha-1-antichymotrypsin regulatory region must be very limited. PMID: 20378355
- The ANTICHYMOTRYPSIN genotype and allele frequency are not different in Indian cerebral hemorrhage and cerebral ischemia compared to controls. PMID: 19959196
- No cirrhosis secondary to ACT deficiency has been reported in children. PMID: 20158662
- AAT efficiently inhibits both heat- and chemical-induced aggregation of various test proteins. PMID: 20117085
- The rs4934 polymorphism of SERPINA3 is not associated with sporadic intracranial aneurysms among individuals of Chinese Han ethnicity. PMID: 19907165
- alpha(1)-antichymotrypsin polymorphism: a risk factor for hemorrhagic stroke in normotensive subjects. PMID: 11692021
- A25G and G39A substitutions in the AACT gene are probably one of the risk factors to Alzheimer's disease (AD) in Han Chinese. PMID: 11798857
- no association seen between alpha 1-antichymotrypsin and time to psychosis in Alzheimer's disease PMID: 11936240
- significantly higher in plasma of Alzheimer patients compared to controls PMID: 11959399
- data suggested that the ApoE epsilon2/epsilon4 genotype might be a susceptibility variant of moderate effect for sporadic idiopathic Parkinson disease in our samples, whereas the ACT gene signal peptide polymorphism might not PMID: 11992569
- Gene regulation of the serine proteinase inhibitors alpha1-antitrypsin and alpha1-antichymotrypsin. PMID: 12023832
- alpha(1)-antitrypsin and antichymotrypsin are produced by the mammary gland and are present in milk in relatively high amounts in early lactation PMID: 12324297
- Polymeric AACT specifically seeds the polymerization of native protein by a serpin-dependent process that occurs under physiological conditions and may be important in the deposition of AACT in plaques in patients with Alzheimer's disease. PMID: 12600202
- overexpression of ACT by astrocytes could thus contribute to increased beta-amyloid fibril formation in Alzheimer's disease PMID: 15530656
- Alpha1-antichymotrypsin-AA may confer a modest protection against developing early-onset Parkinson disease in women PMID: 15542006
- Multivariate analysis showed that ACT mRNA level, but not STC2 mRNA level, in HR-positive patients, was a significant prognostic factor (P = 0.042), which was independent of tumor size and lymph node metastases. PMID: 15546506
- The ACT TT promoter genotype was associated with an increased risk of EOAD independently from the presence of the apolipoprotein E (APOE) epsilon 4 allele. PMID: 15653173
- serpin/furin complex stability depends on pH and regulation at the deacylation step PMID: 15659365
- the A/T polymorphism of SERPINA3 gene is associated with the risk factor for aneurysmal subarachnoid hemorrhage PMID: 15718509
- The onset of MSA was significantly earlier and the disease progressed significantly faster in patients with ACT-AA genotype than in those with non-ACT-AA genotypes. The ACT concentration in cerebrospinal fluid was increased in patients with ACT-AA. PMID: 15907346
- This study findings suggest that ACT polymorphism (A/T) is a risk factor for post-stroke dementia. PMID: 15935385
- AP-1 is a key transcription factor that, in part, controls astrocyte-specific expression of genes including the ACT and GFAP genes PMID: 16303762
- SERPINA3 polymorphism does not have a role in primary intracerebral hemorrhage in a Polish population PMID: 16424370
- NFI-X cooperates with (activator protein 1)AP-1 by an unknown mechanism in astrocytes, which results in the expression of a subset of astrocyte-specific genes. PMID: 16565071
- acute myocardial infarction from information on functional gene variants that favor inflammation or modulate cholesterol metabolism: IL6 -174 G/C, TNF -308 G/A, IL10 -1082 G/A, SERPINA3 -51 G/T, IFNG +874 T/A, HMGCR -911 C/A, and APOE epsilon2/3/4 PMID: 18056971
- We conclude that APOE is a risk gene for amnestic mild cognitive impairment and that ACT and CHRNA7 may act in these patients as modifier genes for the time of progression to Alzheimer's disease. PMID: 18078695
- Nur77 overexpression and RNA interference-mediated Nur77 gene knockdown analysis confirmed that SerpinA3 is indeed a novel Nur77-targeted gene. PMID: 18248459
- A correlation of PSA levels and the alpha 1 antichymotrypsin genotype in young prostate carcinoma patients was found. PMID: 18383875
- Alpha-1-antichymotrypsin is a pathophysiologic inhibitor that controls MMP-9 activation in skin tissue. PMID: 18401426
- Our study did not show an association between alpha-1 antichymotrypsin signal peptide A/T polymorphism and primary intracerebral hemorrhage. PMID: 18408372
- increased peripheral ACT levels in APOE 4 positive patients appear to predict an accelerated clinical progression PMID: 18991685
- Ox-ACT promotes release of human monocyte chemoattractant protein-1 (MCP-1) and IL-8 from human lung type epithelial cells (A549) and normal human bronchial epithelial (NHBE) cells PMID: 19525388
- Using shotgun mass spectrometry, we found this protein differentially expressed in the dorsolateral prefrontal cortex from patients with schizophrenia. PMID: 19165527
顯示更多
收起更多
-
亞細胞定位:Secreted.
-
蛋白家族:Serpin family
-
組織特異性:Plasma. Synthesized in the liver. Like the related alpha-1-antitrypsin, its concentration increases in the acute phase of inflammation or infection. Found in the amyloid plaques from the hippocampus of Alzheimer disease brains.
-
數據庫鏈接:
Most popular with customers
-
Phospho-YAP1 (S127) Recombinant Monoclonal Antibody
Applications: ELISA, WB, IHC
Species Reactivity: Human
-
-
-
-
-
-
VDAC1 Recombinant Monoclonal Antibody
Applications: ELISA, WB, IHC
Species Reactivity: Human, Mouse, Rat
-